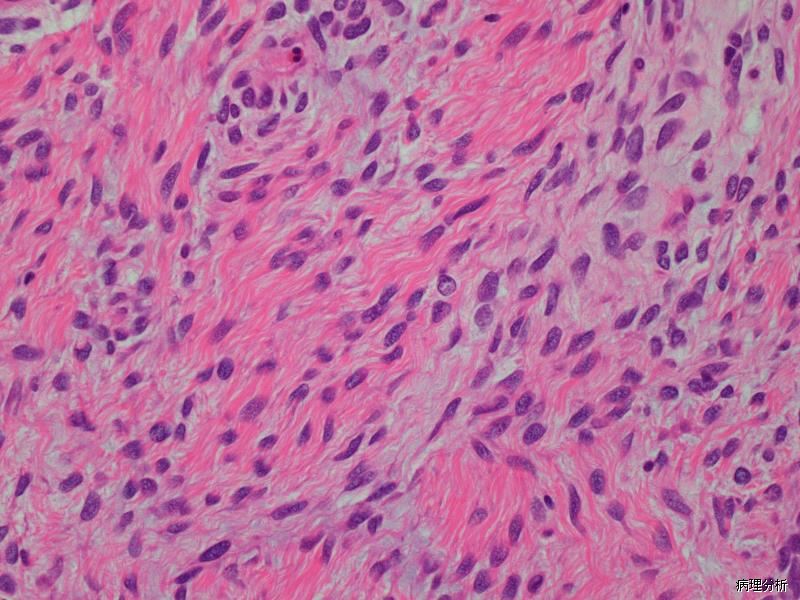

低级别纤维黏液样肉瘤
Low-Grade Fibromyxoidsarcoma,LGFMS
概述:
是纤维肉瘤的一种特殊变型,由形态上类似良性的梭形纤维母细胞样细胞所组成,瘤细胞常呈漩涡状排列,间质呈交替的胶原样和黏液样。
发病部位: 多数病例位于大腿、躯干(胸部肩背部和腋下)、臀部和腹股沟,少数病例位于上肢、外阴、肛周、大网膜、肠系膜、阔韧带、腹膜后、头颈部和直肠等处
诊断要点:
- 可发生于任何年龄段,青年人多见;
- 好发于大腿、躯干,多位于筋膜下或肌肉内;
- 大体上常界限清楚,无包膜;
- 低倍镜下,肿瘤由交替分布的胶原样和黏液样区域混合组成,以胶原样区域为主,两种区域之间有移行或过渡现象,也可有相对清晰的界线;
- 瘤细胞常漩涡状排列或呈线形排列,也可杂乱分布;
- 肿瘤细胞形态较一致,呈梭形或短梭形,在黏液样区域内还可呈星状,类似纤维母细胞,胞质呈淡嗜伊红色,胞界不清,可呈纤细的原纤维状,核呈圆形或卵圆形,深染,染色质分布均匀,有时可见小的核仁;核的异型性不明显,核分裂像少见;
- 间质血管较少,多呈拱状、曲线状或弧线状,血管周可伴有玻璃样变性;
- 在黏液样区域内,有时可见类似黏液性脂肪肉瘤中的分支状毛细血管网;
- 部分病例局部区域瘤细胞可显示一定程度的多形性,并可见血管周围瘤细胞聚集现象;
10.40%的肿瘤内可见散在的类圆形或不规则的巨大菊形团,其中央为胶原纤维,嗜伊红色,双折光性,呈放射状排列,周围环绕以圆形或卵圆形细胞,也呈放射状排列,形成单层或多层细胞套; - 肿瘤细胞可向邻近的组织内浸润性生长;
- 一些复发或转移的病例,瘤细胞的密度明显增加,并可见核分裂像。

免疫组织化学染色:
MUC4 和 DOG1 阳性; desmin、S-100. CK、EMA、 CD34 等阴性。
分子标记:
大多数可见 t(7;16)(q32-34;p11)和 FUS-CREB3L2 融合,少数可见 t(11;16)(p11;p11)和 FUS-CREB3L1
鉴别诊断:
- 韧带样纤维瘤病 :无特征性的胶原和黏液交替性分布现象,也不见巨菊形团结构。纤维瘤病中的瘤细胞除 vimentin 和 actins 外,还可表达核 β-catenin。
- 硬化性纤维瘤 :周界清晰,可有纤维性假包膜,瘤内细胞密度低,细胞无异型性,间质内含有大量的胶原纤维。
- 硬化性上皮样纤维肉瘤 :以间质出现明显的硬化和夹杂其间呈条索状排列的圆形或多边形上皮样瘤细胞为特征,部分病例显示与低度恶性纤维黏液样肉瘤杂合或过渡的组织学特征。
- 低级别黏液纤维肉瘤:黏液间质更明显,瘤细胞异型性更大,常见围绕血管周围分布,可见充满黏液的假脂肪母细胞。
治疗:
扩大切除保证阴性切缘,长期随访
参考文献:
Evans H L. Low-grade fibromyxoid sarcoma: a clinicopathologic study of 33 cases with long-term follow-up[J]. American Journal of Surgical Pathology, 2011, 35(10):1450-1462.
← 纤维母细胞性结缔组织痣 皮肤多形性纤维瘤 →
